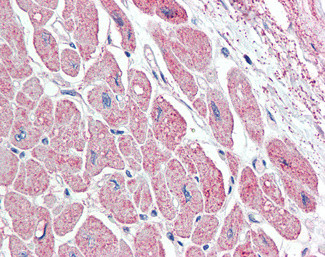
ANP Antibody in Immunohistochemistry (Paraffin) (IHC (P))

Search
Invitrogen
ANP Polyclonal Antibody
{{$productOrderCtrl.translations['antibody.pdp.commerceCard.promotion.promotions']}}
{{$productOrderCtrl.translations['antibody.pdp.commerceCard.promotion.viewpromo']}}
{{$productOrderCtrl.translations['antibody.pdp.commerceCard.promotion.promocode']}}: {{promo.promoCode}} {{promo.promoTitle}} {{promo.promoDescription}}. {{$productOrderCtrl.translations['antibody.pdp.commerceCard.promotion.learnmore']}}
产品信息
PA5-142816
种属反应
宿主/亚型
分类
类型
抗原
偶联物
形式
浓度
规格
纯化类型
保存液
内含物
保存条件
运输条件
RRID
产品详细信息
Additional Information: The immunizing peptide represents aa137-150 of the precursor NPPA.
This antibody is tested in Peptide ELISA: antibody detection limit dilution 1:32,000.
靶标信息
The protein encoded by this gene belongs to the natriuretic peptide family. Natriuretic peptides are implicated in the control of extracellular fluid volume and electrolyte homeostasis. This protein is synthesized as a large precursor (containing a signal peptide), which is processed to release a peptide from the N-terminus with similarity to vasoactive peptide, cardiodilatin, and another peptide from the C-terminus with natriuretic-diuretic activity. Mutations in this gene have been associated with atrial fibrillation familial type 6.
仅用于科研。不用于诊断过程。未经明确授权不得转售。
篇参考文献 (0)
生物信息学
蛋白别名: atrial natriuretic factor; Atrial natriuretic factor prohormone; atrial natriuretic peptide; Atrial natriuretic peptide prohormone; Atriopeptigen; atriopeptin; Cardiodilatin; cardiodilatin-related peptide; cardionatrin; CDD; natriuretic peptide precursor A; Natriuretic peptide precursor A (pronatriodilatin, also Anf, Pnd); natriuretic peptide precursor A variant NPPA-M1; natriuretic peptide precursor A variant NPPA-M2; natriuretic peptide precursor A variant NPPA-M3; natriuretic peptide precursor type A; Natriuretic peptides A; preproANF; preproANP; preprocardiodilatin-atrial natriuretic factor; preproCDD-ANF; prepronatiodilatin (PND); prepronatriodilatin; proANF; proANP; Pronatriodilatin; urodilatin
基因别名: ANF; ANP; ATFB6; ATRST2; CDD; CDD-ANF; CDP; NPPA; PND; RATANF
UniProt ID: (Human) P01160, (Rat) P01161, (Mouse) P05125
Entrez Gene ID: (Human) 4878, (Rat) 24602, (Mouse) 230899